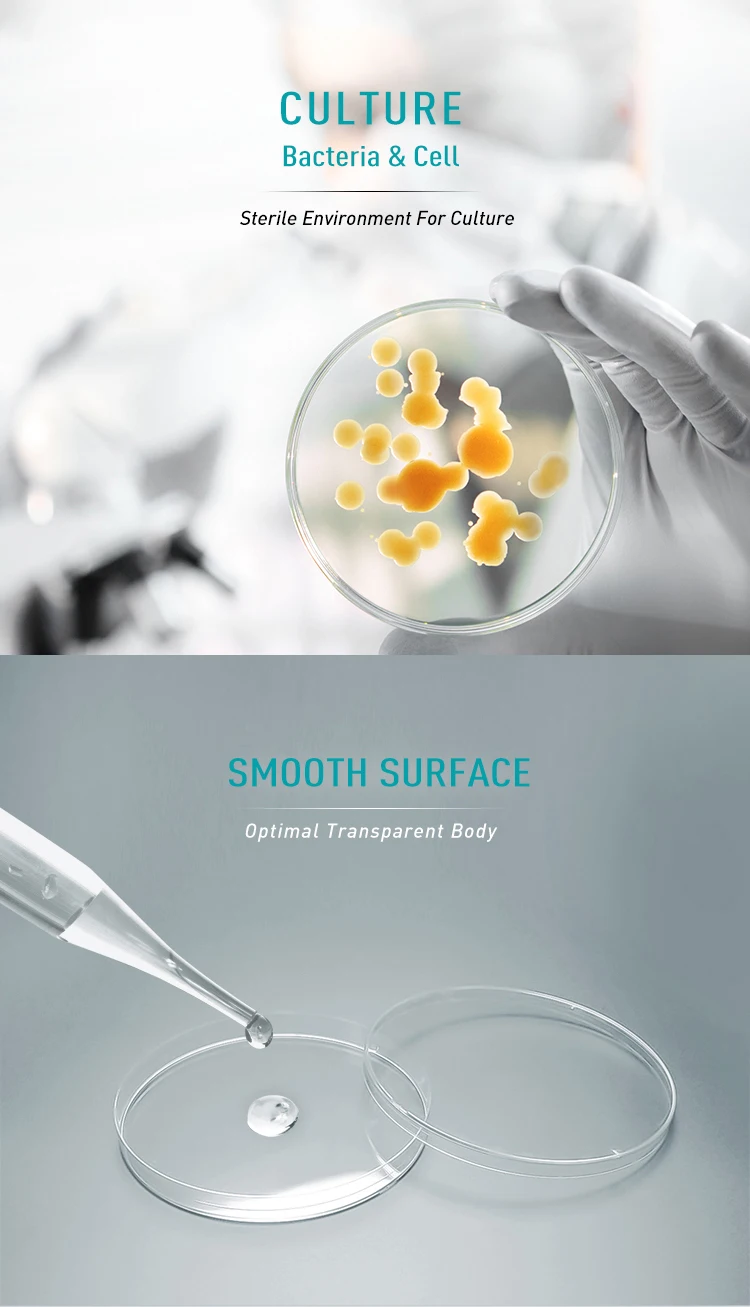

| Port: | Shanghai,Ningbo etc; | Place of Origin: | Jiangsu China; |
| Payment Terms: | L/C,T/T,Western Union; | Supply Ability: | 400000 Piece/Pieces per Month Petri Dish; |
| Brand Name: | OEM; | Material: | PS; |
| Classification: | Petri Dish; | Name: | China top medical equipment supplier wholesale custom big petri dish; |
| Diameter: | 35-150mm; | Model Number: | Petri Dish; |
| Packaging Detail: | Neutral export package for China top medical equipment supplier wholesale custom big petri dish; | Color: | Transparent; |
China top medical equipment supplier wholesale custom big petri dish

Made of high transparency medical grade PS material, Used for fungus, bacteria and other microorganism culture.
Superior production technique makes the dish thickness uniform. The dish bottom is smooth and clean without deformation, which makes the quantitative analysis more precise.
Easy to stack up with the stack up circle.
Vent design for easy air exchange.
E.O sterile available.
Item No. | Description | Spec. | Qty/Cs |
X201 | Petri Dish | 13×13cm | 1pcs/bag × 200bags |
X201-2 | Petri Dish | Φ150 | 1pcs/bag × 110bags |
X202 | Petri dish | Φ90(18g) | 10pcs/bag × 50bags |
X202-1 | Petri dish | Φ90(14g) | 10pcs/bag × 50bags |
X202-3 | Petri dish | Φ90(Dialysis Paper) | 10pcs/bag × 50bags |
| X202-2 | Petri dish | Φ90 | 10pcs/bag × 50bags |
| X203 | Petri dish | Φ90(2 Compartments) | 10pcs/bag × 50bags |
| X204 | Petri dish | Φ90(3 Compartments) | 10pcs/bag × 50bags |
| X205-1 | Petri dish | Φ70(10g) | 10pcs/bag × 100bags |
| X206 | Petri dish | Φ60 | 10pcs/bag × 100bags |
| X207-1 | Petri dish | Φ35 | 10pcs/bag × 300bags |
| X207 | Siamese Petri Dish | Φ35 | 200set/box |
| X207-2 | Petri Dish | Φ80 × 25 | 10pcs/bag × 60bags |

Q: Can you produce according to customers' design?
Yes, we are professional manufacturer; OEM and ODM are both welcomed.
1) Customized Color box;
2) Any your Idea on product we can help you to design and put it into production.
Q: What about your after Sale Service:
1) All products will have been strictly Quality Checked in house before packing.
2) All products will be well packed before shipping.
Q: Why choose us?
Professional supplier on fitness products;
Lowest factory price with good quality;
Low MOQ for start small business;
Free sample to check quality;
Meet safety standard for Europe and USA;
Special technology on print;
Accept trade assurance order to protect buyer;
On-time delivery.
Q: What is advantange on quality?
High quality sticky to secure your hands and feet during yoga;
The non slip surface provides a safe and comfortable surface for you to practice any pose;
Eco-friendly material;
Good resilience force;
Odourless;
Ultra+dry grip;
Easy clean .

China top medical equipment supplier wholesale custom big petri dish